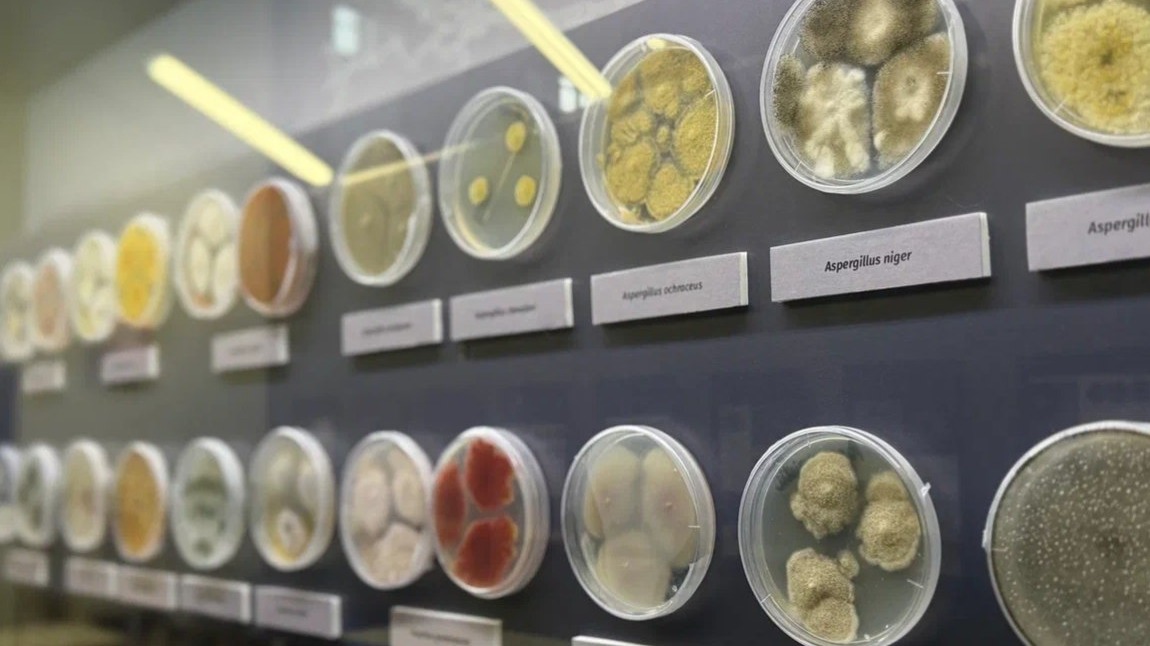
Москвичей пригласили на необычную выставку о плесени в столичный биокластер

Москвичей пригласили на необычную выставку о плесени в столичный биокластер
В биокластере на ВДНХ открылась необычная выставка «Тайная жизнь плесени: микромицеты жилых помещений». В павильоне № 31 «Геология» представлены живые культуры микроскопических грибов. Экспозиция будет работать до 30 ноября.
На выставке вместо традиционных экспонатов представлены научные образцы, которые в закрытых чашках Петри продолжают расти и меняться каждый день.
Экспозиция демонстрирует необычные свойства микромицетов. Некоторые виды грибов участвовали в космических экспедициях, а плесень рода Penicillium позволила британскому ученому Александру Флемингу открыть пенициллин.
Выставка также объясняет методы работы с микромицетами. Посетители узнают о сборе проб микроорганизмов, «чистых культурах» и способах хранения культур, передает «КП».
В октябре текущего года биокластер на ВДНХ приглашал школьников провести осенние каникулы с пользой. В павильоне № 29 «Цветоводство и озеленение» научные сотрудники провели занятия, на которых ребята смогли узнать больше о мире растений, насекомых и природе.